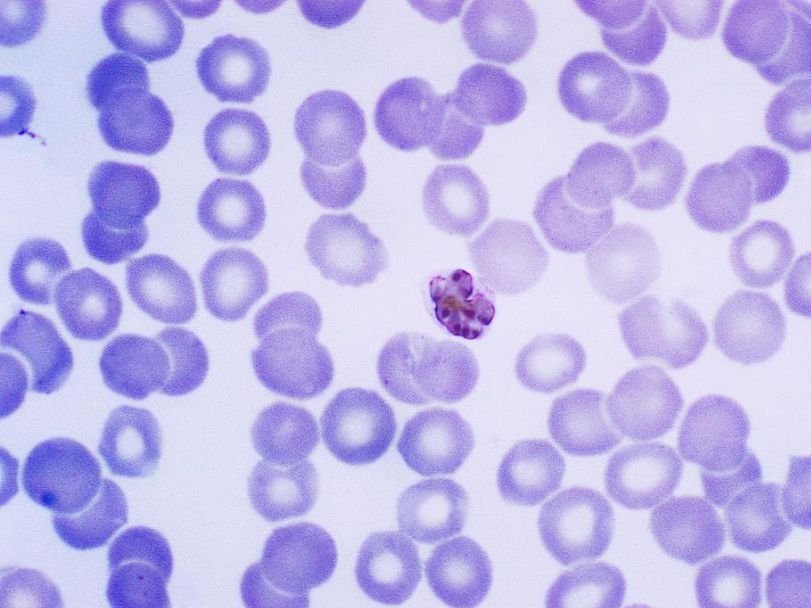

Максим Руссо: Малярия, эволюция, янтарь
Plasmodium malariae Wikimedia Commons Участники застольных бесед Плутарха обсуждали разнообразные занятные вопросы. Самый знаменитый из них – что было раньше курица или яйцо? Современные биологи заняты куда более осмысленными и интересными вопросами. Например, одноклеточное существо, вызывающее малярию, паразитирует, как известно, в организме комара и человека. Но в чьем организме оно завелось изначально, а к кому проникло потом?
Конечно, биологи понимают, что малярийный плазмодий (Plasmodium), не перешел к паразитизму в какой-то один момент, а такой образ жизни вели и его предки. Просто возбудители малярии в результате мутаций приобрели способность жить и в человеческом организме. Но это не отменяет наш вопрос, а лишь переводит его на более высокий уровень. Ведь все представители гемоспоридий, или кровяных споровиков, (Haemospororida) – отряда, к которому относится малярийный плазмодий, ведут сходный образ жизни. Они паразитируют в крови позвоночных животных и в организме кровососущих насекомых. Среди хозяев гемоспоридий есть и рептилии, и птицы, и млекопитающие (преимущественно, грызунов и приматов). В одном только роде Plasmodium более 200 видов. К ним, например, относится Plasmodium galinaceum, вызывающий тяжелое заболевание кур, или Plasmodium relictum – возбудитель другого типа птичьей малярии.
В 1972 году ученые описали в Индии новый вид гемоспоридий, живущий в крови пресноводной рыбы Ophicephalus punctatus. Это очень необычно, так как рыб не кусают обычные переносчики малярии – двукрылые насекомые. Вид получил название Mesnilium malariae. Исследователи предположили, что в данном случае в качестве второго хозяина могли выступать кровососущие пиявки, но пока это не доказано. По другой гипотезе, рыбы становятся случайными хозяевами паразита, поедая насосавшихся крови самок комаров. Для решения этого вопроса данных пока недостаточно.
Итак, нас интересует, был ли момент, когда жившие в крови древних рептилий древние гемоспоридии попали в организм не менее древних кровососущих насекомых, или же все было наоборот – древние гемоспоридии жили в организме древних насекомых, а когда те стали сосать кровь рептилий, попали туда и приспособились жить на два дома.
Мы напомним, как выглядит цикл развития гемаспоридий, на примере возбудителя человеческой малярии. Болезнь человека вызывают лишь пять видов плазмодиев: Plasmodium vivax, Plasmodium falciparum, Plasmodium ovale, Plasmodium malariae и Plasmodium knowlesi, который также живет в организме длиннохвостого макака (Macaca fascicularis). P. ovale может передаваться шимпанзе, а P. vivax – шимпанзе и орангутангам, вызывая ослабленную форму болезни. Обычно же плазмодии придерживаются одного хозяин и не поражают других животных. И, соответственно, виды плазмодия, паразитирующие в крови других видов, безопасны для человека. Генетически ближайшими предками человеческих плазмодиев оказывают плазмодии, которые живут в организме горилл. Переносчиком малярии человека служат комары рода Anopheles.
После укуса самки комара плазмодий попадает в кровь человека. Он представляет собой вытянутую клетку длиной 10 – 15 микрометров при ширине всего в один микрометр. С кровью плазмодий рано или поздно попадает в печень. Там он внедряется в клетки печени, растет и делится. Получающиеся в результате новые клетки также внедряются в клетки печени. Так проходит одно или несколько поколений бесполого размножения в клетках печени. Наконец, после очередного деления новое поколение клеток внедряется уже не в клетки печени, а в эритроциты.
Зараженные эритроциты плывут по кровеносным сосудам, а внутри них живут и снова и снова делятся клетки плазмодия. На этот раз они гораздо меньшего размера – диаметром примерно два микрометра. Наконец, оболочка эритроцита лопается, и клетки плазмодия вновь попадают в кровь. Поражает синхронность этого процесса. Plasmodium vivax, Plasmodium falciparum и Plasmodium ovale прорывают эритроциты и выходят в кровь каждые 48 часов, Plasmodium malariae – каждые 72 часа. Именно в эти моменты у человека начинается приступ – повышается температура, появляется озноб и так далее. Это объясняется тем, что в кровь попадают токсические вещества – продукты жизнедеятельности плазмодия, которые раньше находились внутри оболочки эритроцита. Клетки плазмодия вновь внедряются в эритроциты и приступают к делению. Цикл начинается заново, и с каждым разом поражается всё больше эритроцитов.
Но бесполое размножение плазмодия не продолжается бесконечно. После нескольких циклов обычные клетки плазмодия превращаются в так называемые микрогаметоциты и макрогаметоциты, которые дадут начало мужским и женским половым клеткам. Чтобы началась половая фаза размножения, эти клетки должны попасть в кишечник комара. Там происходит оплодотворение, и оплодотворенная клетка (ооциста) закрепляется на стенке кишечника. Она растет, увеличиваясь в сотни раз, а внутри нее многократно делится ядро. Наконец, в клетке образуется огромное количество маленьких одноядерных клеток – спорозоитов, она прорывается, и спорозоиты, червеобразно изгибаясь, устремляются в слюнные железы комара. Из одной оплодотворенной клетки может получиться до 10 тысяч спорозоитов. Когда комар вновь укусит человека, спорозоиты попадут в его кровь, устремятся в печень и цикл развития малярийного плазмодия повторится. У плазмодия есть еще один вариант развития, открытый лишь в 1980-х годах. Это так называемые гипнозоиты, «спящие клетки», которые находятся в покоящемся состоянии внутри клеток печени и могут стать причиной возвращения заболевания годы спустя.
Жизненный цикл возбудителя малярии Plasmodium falciparum
Наиболее древними позвоночными, в крови которых могут жить гемоспоридии, оказываются рептилии. Палеонтологи обнаружили в бирманском янтаре мелового периода останки представителей рода Protoculicoides из семейства мокрецов (Ceratopogonidae), в организме которых нашли гемоспоридий, получивших название Paleohaemoproteus burmacis. Судя по анатомическому строению ротового аппарата, эти мокрецы кусали рептилий (да и млекопитающие в меловом периоде были немногочисленны).
Мокрец из рода Protoculicoides в янтаре. Стрелка показывает скопление ооцист плазмодия
Ооцисты (слева) и спорозоиты (справа) из брюшной полости этого мокреца
Нашел их палеоэнтомолог, известный специалист по находкам в янтаре Джордж Пойнар (George Poinar, Jr.) из Орегонского университета, о работах которого нам уже не раз приходилось рассказывать. Пойнар и Сэм Телфорд (Sam R. Telford III), который специализируется на паразитах крови у животных, сумели разглядеть в полости тела заключенного в янтаре древнего мокреца 35 ооцист. Некоторые из них уже разорвались, и оттуда выходили спорозоиты, что доказывает наличие половой стадии размножения паразита в организме насекомого еще 100 млн. лет назад.
Специалисты давали разные ответы на вопрос о развитии паразитизма со сменой хозяина у гемоспоридий. Если в 1940-х годах высказывали мнение, что первыми их хозяевами были насекомые, то в потом долгое время преобладала точка зрения, что гемоспоридии появились у рептилий, а недавно некоторые авторы вновь стали склоняться к первичности насекомых. Серьезным аргументом в пользу этого варианта служит тот факт, что половая стадия развития у плазмодиев и прочих гемоспоридий происходит только в организме насекомого и никогда – в позвоночных.
Помочь дать ответ на вопрос могла бы точная классификация гемоспоридий и их возможных родственников, которых обычно объединяют в тип апикомплексов (Apicomplexa). Дело в том, что, установив ближайших родственников гемоспоридий, можно будет сделать вывод о том, где жили древнейшие их представители. На эту роль претендуют две группы: кокцидии и грегарины. Кокцидии (Coccidia) способны жить в организме позвоночных, хотя встречаются и у членистоногих, моллюсков и даже кольчатых червей. Самый знаменитый их представитель – токсоплазма (Toxoplasma gondii), предпочитающая жить в кошках, а в качестве промежуточных хозяев использующая других млекопитающих или же птиц. Грегарины (Gregarine) же напротив специализируются на паразитировании в беспозвоночных, очень часто – именно в насекомых. Если гемоспоридии окажутся эволюционно близки к грегаринам, значит и они начинали свою карьеру в организме насекомых.
Но построить эволюционное древо апикомплексов по данным ДНК пока нельзя из-за нехватки материала. Геномы всех возбудителей человеческой малярии уже прочитаны, но сотни других видов пока ждут своей очереди. В результате полное дерево пока не построено, часть ветвей непонятно, куда присоединить, а у других неясен порядок ветвления. Для определения эволюционных взаимоотношений часто используют последовательность рибосомальной РНК, но у плазмодиев и других гемоспоридий есть несколько вариантов рибосомальной РНК, которые экспрессируются на разных стадиях жизненного цикла и способны рекомбинировать друг с другом, что еще более осложняет задачу. Используют также и циркумспорозоитный белок, который есть у всех видов плазмодиев, но данный белок, находится на поверхности клетки плазмодия и поэтому подвергается сильному селективному давлению иммунной системы хозяина, что может скрыть важные изменения.
Пока, как удалось установить японским ученым, построившим филогенетическое древо части гемоспоридий на основе гена, кодирующего белок цитохром b, общий предок родов Plasmodium, Haemoproteus и Hepatocystis жил в крови представителей отряда чешуйчатых, то есть змей и ящериц. Потенциальными его переносчиками могли быть все те же мокрецы (наиболее древняя группа), а также москиты (Phlebotominae), комары (Culicidae) или слепни (Tabanidae).
В недавней публикации в журнале American Entomologist Джордж Пойнар подытоживает известные к настоящему моменту факты и пытается сделать выбор в пользу кокцидий или гренадин как предков гемоспоридий. Он отмечает, что кокцидии хотя и живут порой в организме насекомых, не встречаются у представителей отряда двукрылых – переносчиков малярийного плазмодия и других гемоспоридий. Единственный известный вид двукрылых, заражаемый кокцидиями – Tipula abdominali, в личинках которого живет открытая в 1947 году кокцидия Ithania wenrichi. Блохи способны переносить кокцидий, но в их организме кокцидии не размножаются, ни половым, ни бесполым путем. Ни у какой из групп насекомых, которые переносят гемоспоридий, кокцидии не встречаются.
Грегарины, напротив, у комаров, мокрецов и москитов широко встречаются, а жизненный цикл одной из их групп (Neogregarinorida) состоит из полового и бесполого поколений, напоминающих стадии жизненного цикла гемоспоридий. Есть схожие случаи и в другой группе (Eugregarinorida), например вид Ascogregarina culicis, живуший в комарах. Он не меняет хозяев, но различные стадии его жизненного цикла проходят в личинке, куколке и взрослой особи комара. При этом в личинке и куколке происходит бесполое, а в организме взрослого насекомого половое размножение.
В вышедшей в 2013 году под редакцией Изабель Деспорт (Isabelle Desportes) и Жозефа Шревеля (Joseph Schrével) фундаментальной монографии о гренадинах отмечался ряд черт, объединяющих некоторые виды гренадин с гемоспоридиями. В их число входят особенности строения мембран, структура некоторых белков, процесс образования жгутиков. Основываясь на всех этих доводах, Пойнар склоняется к гипотезе родства гемоспоридий с гренадинами, а значит к тому, что первичными хозяевами их были насекомые.
Смотрите также: В организме североамериканских оленей обнаружен возбудитель малярии Генетики Калифорнии сделают комаров неспособными переносить малярию Александра Брутер Новое лекарство от малярии Максим Руссо Новый этап борьбы с малярией